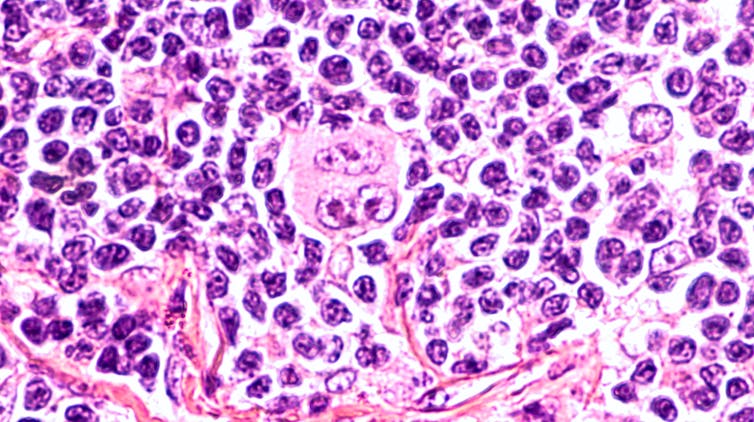

El extraño caso de la curación de un linfoma de Hodgkin por el SARS-CoV-2
Ignacio López-Goñi, Universidad de Navarra
Se acaba de publicar en el British Journal of Haemathology el siguiente caso clínico: Varón de 61 años con inflamación de los ganglios y pérdida de peso, recibía hemodiálisis por insuficiencia renal terminal después de un trasplante renal fallido. Se le diagnostica un linfoma de Hodgkin clásico en estadio III (el linfoma afecta a áreas ganglionares localizadas a ambos lados del diafragma o por encima del diafragma y en el bazo).
Poco después del diagnóstico, ingresó con dificultad para respirar y se le diagnosticó neumonía por SARS-CoV-2 positivo por PCR. Después de once días, fue dado de alta para convalecer en su casa. No se administró corticosteroides ni inmunoquimioterapia.
Cuatro meses después, la inflamación de los ganglios se había reducido y una exploración PET reveló una remisión generalizada del linfoma.
Según los autores, la hipótesis es que la infección por SARS-CoV-2 desencadenó una respuesta inmunitaria antitumoral: las citocinas inflamatorias producidas en respuesta a la infección podrían haber activando células T específicas con antígenos tumorales y células asesinas naturales contra el tumor. El SARS-CoV-2 le había curado el linfoma.
¿Magía potagía?
Por lo visto antes ya se había descrito algún caso similar en otro tipo de linfomas que habían remitido espontáneamente antes de tratamiento debido al efecto antitumoral de una neumonía infecciosa y de una colitis por Clostridium difficile.
En el fondo esto no es tan sorprendente. Los microorganismos no solo pueden causar cáncer, sino que también pueden ayudar a curarlo. A finales del siglo XIX un médico de Nueva York llamado William B. Coley desarrolló un tratamiento contra el cáncer con un preparado de bacterias llamado las toxinas de Coley.
Este médico se dio cuenta de que los pacientes con cáncer que además sufrían una infección respondían mejor que los pacientes sin infección. Coley pensaba que la infección estimulaba el sistema inmune para luchar contra el cáncer y por eso desarrolló un cóctel de bacterias Streptococcus pyogenes y Serratia marcescens, que inyectaba directamente en el tumor. Durante años en EE. UU. se trató a pacientes de algunos tipos de cáncer incurables con preparados de bacterias y toxinas, en muchos casos de forma exitosa.

Sin embargo, las críticas y sobre todo el éxito de los nuevos tratamientos de quimio y radioterapia hizo que las toxinas de Coley cayeran en el olvido. No obstante, actualmente se ha comprobado que el principio básico del tratamiento de Coley era correcto y que algunos tipos de cáncer son sensibles a una estimulación del sistema inmune.
En el fondo todo está relacionado: los microbios, el sistema inmune, la respuesta inflamatoria y el cáncer, pero todavía no sabemos muy bien cómo. En las últimas décadas se ha empleado el bacilo Calmette-Guerin, más conocido por sus siglas BCG, como tratamiento contra el cáncer de vejiga. El BCG es en realidad un extracto atenuado de la bacteria Mycobacterium bovis que se emplea como vacuna contra la tuberculosis.
El BCG estimula una respuesta inmune y causa la inflamación de la pared de la vejiga que acaba destruyendo las células de cáncer dentro de la vejiga, al menos en los primeros estadios del tumor. En realidad en esto se basa la inmunoterapia, que está tan de moda actualmente. La intuición de Coley era correcta: estimular el sistema inmune puede ser efectivo para tratar el cáncer. Por eso a William B. Coley se le llama «el padre de la inmunoterapia».
Una versión de este artículo fue publicada originalmente en el blog del autor, microBIO.